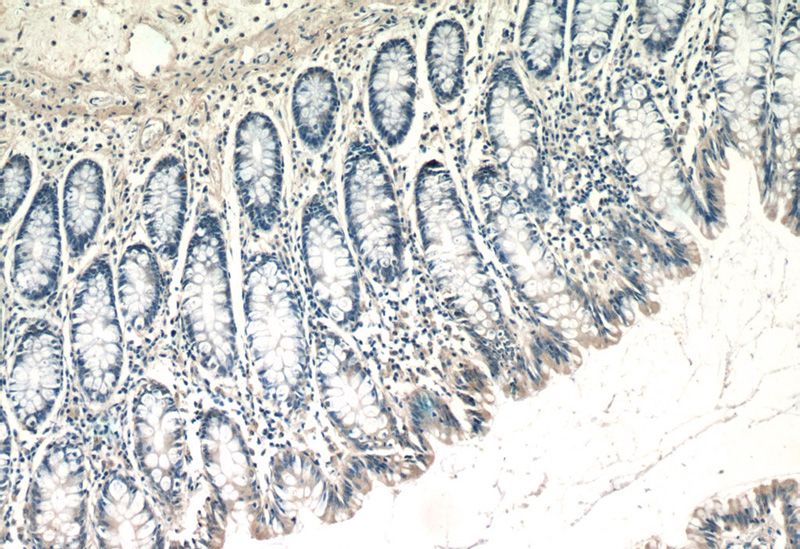
Immunohistochemistry of paraffin-embedded human colon tissue slide using Catalog No:116387(TTC7A Antibody) at dilution of 1:50 (under 10x lens)

-
Product Name
TTC7A antibody
- Documents
-
Description
TTC7A Rabbit Polyclonal antibody. Positive IP detected in K-562 cells. Positive WB detected in K-562 cells, mouse colon tissue, mouse small intestine tissue, PC-3 cells, Transfected HEK-293 cells. Positive IHC detected in human colon tissue. Observed molecular weight by Western-blot: 96 kDa
-
Tested applications
ELISA, WB, IHC, IP
-
Species reactivity
Human, Mouse; other species not tested.
-
Alternative names
KIAA1140 antibody; TPR repeat protein 7A antibody; TTC7 antibody; TTC7A antibody
-
Isotype
Rabbit IgG
-
Preparation
This antibody was obtained by immunization of TTC7A recombinant protein (Accession Number: NM_001288955). Purification method: Antigen affinity purified.
-
Clonality
Polyclonal
-
Formulation
PBS with 0.02% sodium azide and 50% glycerol pH 7.3.
-
Storage instructions
Store at -20℃. DO NOT ALIQUOT
-
Applications
Recommended Dilution:
WB: 1:200-1:1000
IP: 1:200-1:1000
IHC: 1:20-1:200
-
Validations

K-562 cells were subjected to SDS PAGE followed by western blot with Catalog No:116387(TTC7A Antibody) at dilution of 1:300

Transfected HEK-293 cells were subjected to SDS PAGE followed by western blot with Catalog No:116387(TTC7A Antibody) at dilution of 1:500

IP Result of anti-TTC7A (IP:Catalog No:116387, 4ug; Detection:Catalog No:116387 1:300) with K-562 cells lysate 4000ug.
Immunohistochemistry of paraffin-embedded human colon tissue slide using Catalog No:116387(TTC7A Antibody) at dilution of 1:50 (under 10x lens)

Immunohistochemistry of paraffin-embedded human colon tissue slide using Catalog No:116387(TTC7A Antibody) at dilution of 1:50 (under 40x lens)
-
Background
TTC7A (TPR repeat protein 7A) is expressed in enterocytes within the duodenum, ileum, and colon, and has a role in enterocyte survival and function. Mutations in the TTC7A gene can result in a spectrum of intestinal disease, including multiple intestinal atresia (MIA) and very early onset inflammatory bowel diseases (VEOIBD). Functional analysis revealed that TTC7A binds to and facilitates the transport of PI4KIIIa from the trans-Golgi to the plasma membrane, while loss of TTC7A results in dysregulation of PI4KIIIa signaling. This antibody specially recognizes endogenous TTC7A. (24417819)
-
References
- Avitzur Y, Guo C, Mastropaolo LA. Mutations in tetratricopeptide repeat domain 7A result in a severe form of very early onset inflammatory bowel disease. Gastroenterology. 146(4):1028-39. 2014.
Related Products / Services
Please note: All products are "FOR RESEARCH USE ONLY AND ARE NOT INTENDED FOR DIAGNOSTIC OR THERAPEUTIC USE"
